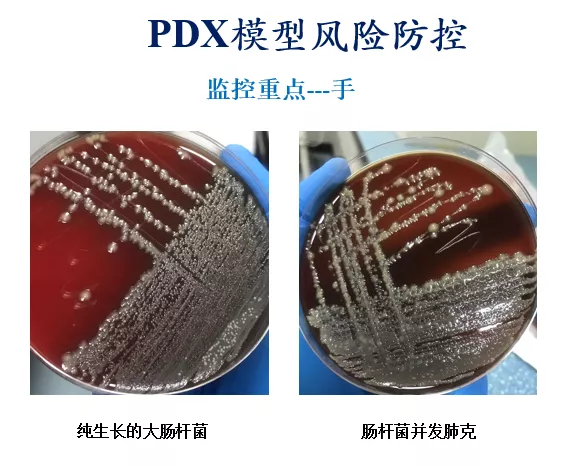

人源肿瘤异种移植(PDX)模型是肿瘤研究的重要工具,近年来在肿瘤研究、新药研发等领域得到了广泛的应用。2020.10.17《中华人民共和国生物安全法》正式颁布,说明国家对生物安全的重视提高到了一个新的高度。PDX模型在构建和使用过程中涉及到很多生物安全问题,是临床医学和实验动物学等多学科的交叉领域,目前尚缺乏系统性的研究,其生物安全防控体系尚待完善。接下来就让我们对研讨会做个简单回顾吧!
PDX生物安全探讨恰逢其时
今天三位专家都不约而同都提到了2020.10.17全国人大刚刚颁布的《中华人民共和国生物安全法》。我们的《PDX模型研究中的生物安全防控线上研讨会》在这个背景下举行,真是恰逢其时!

多元化视角探讨,干货满满
本次研讨会邀请的三位专家,分别从动物设施的生物安全管理、动物房设计和建设中生物安全性考量以及临床外科医生的角度出发,分享他们在工作、研究中对PDX模型研究中的生物安全防控的经验和思考,共同探讨PDX模型构建和应用过程中的生物安全防控问题。
第一位分享嘉宾邵奇鸣博士,拥有多年知名CRO和医药研发公司工作经历,具有丰富的实验动物设施建设和运行管理经验,在实验动物界有很高的声望。

邵博士的报告题目是《从PDX模型构建流程看实验动物设施的生物安全管理及控制》。邵博士从实验室安全问题案例展开,详细介绍了PDX实验流程中存在的生物安全风险点,并给出了相应的预防和管理建议。


邵博士特别强调了个人防护用品(PPE)管理和危险源辨识与风险评价,对PDX模型研究者具有很高的参考意义。


第二位分享嘉宾王晓梅教授,是深圳大学医学部创院元老之一,长期从事实验动物研究和管理工作,特别是在一次性笼具研究和应用方面有深厚造诣。

王教授的报告题目是《实验动物房建设中生物安全性考量及一次性动物饲养笼具应用利益代价分析》。王教授从SPF动物房生物安全隐患开始,继而结合自身负责深圳大学2所实验动物中心筹建工作的经验,介绍了其在实验动物房设计和建设中的安全性考量。


王教授结合其在美国加利福尼亚大学圣地亚哥分校(UCSD)访学时使用一次性笼具饲养动物的感受及其回国后研发、试用国产一次性笼具经历,给大家普及了一次性笼具的相关知识,并对一次性笼具使用的利益代价进行了详细分析。



第三位分享嘉宾是PDX模型实战派高手何远桥博士。何博士是外科医生出身,对各种高难度原位PDX模型的构建具有丰富的经验,其开创的《PDX模型构建手把手培训班》模式在业内广受好评。

何博士的报告题目是《从外科医生角度看PDX模型的生物安全管理》。何博士从《中华人民共和国生物安全法》开始,分析了PDX模型构建和应用过程中的主要生物安全风险点,特别是病院微生物管理、实验动物管理和人类遗传资源管理这三个方面。然后重点分析了临床肿瘤患者合并感染的情况,特别是乙肝、肺结核和艾滋病这3种常见法定传染病与肿瘤的关系。


其次,何博士从外科医生的角度谈到了手术前后肿瘤样本采集的注意事项、模型构建过程中的安全防控。着重指出了需要重点监控技术人员的手、接种器械以及实验室电脑的键盘和鼠标。

热烈的交流、合作的开始
3位分享嘉宾9:00试麦时就开始了热烈的交流。对于PDX模型的生物安全防控这个问题,3位嘉宾都是关注了很久,但一直没有找到一个合适的交流机会,今天有了这个交流机会一开始就刹不住车,直到会议快要正式开始才结束。线上几位老师都对一次性笼盒的使用感兴趣,问了王教授不少问题。分享嘉宾何博士抛出来的两个问题:乙肝病毒是否会随着PDX传代而减弱以及普通液氮罐(非气相)冻存PDX模型肿瘤组织的安全性也引起了大家的讨论热情。最后王教授和何博士还就PDX模型中的乙肝病毒问题初步达成了合作意向。

专家们的精彩演讲、老师们的积极参与和劈棒客项目小伙伴们的付出让这次PDX模型生物安全防控研讨会圆满结束,感谢所有关注这次研讨会的你们,希望今天的研讨会能为我国PDX模型的生物安全标准和防控体系的建立提供参考!
点击链接获得研讨会PDF哦~






